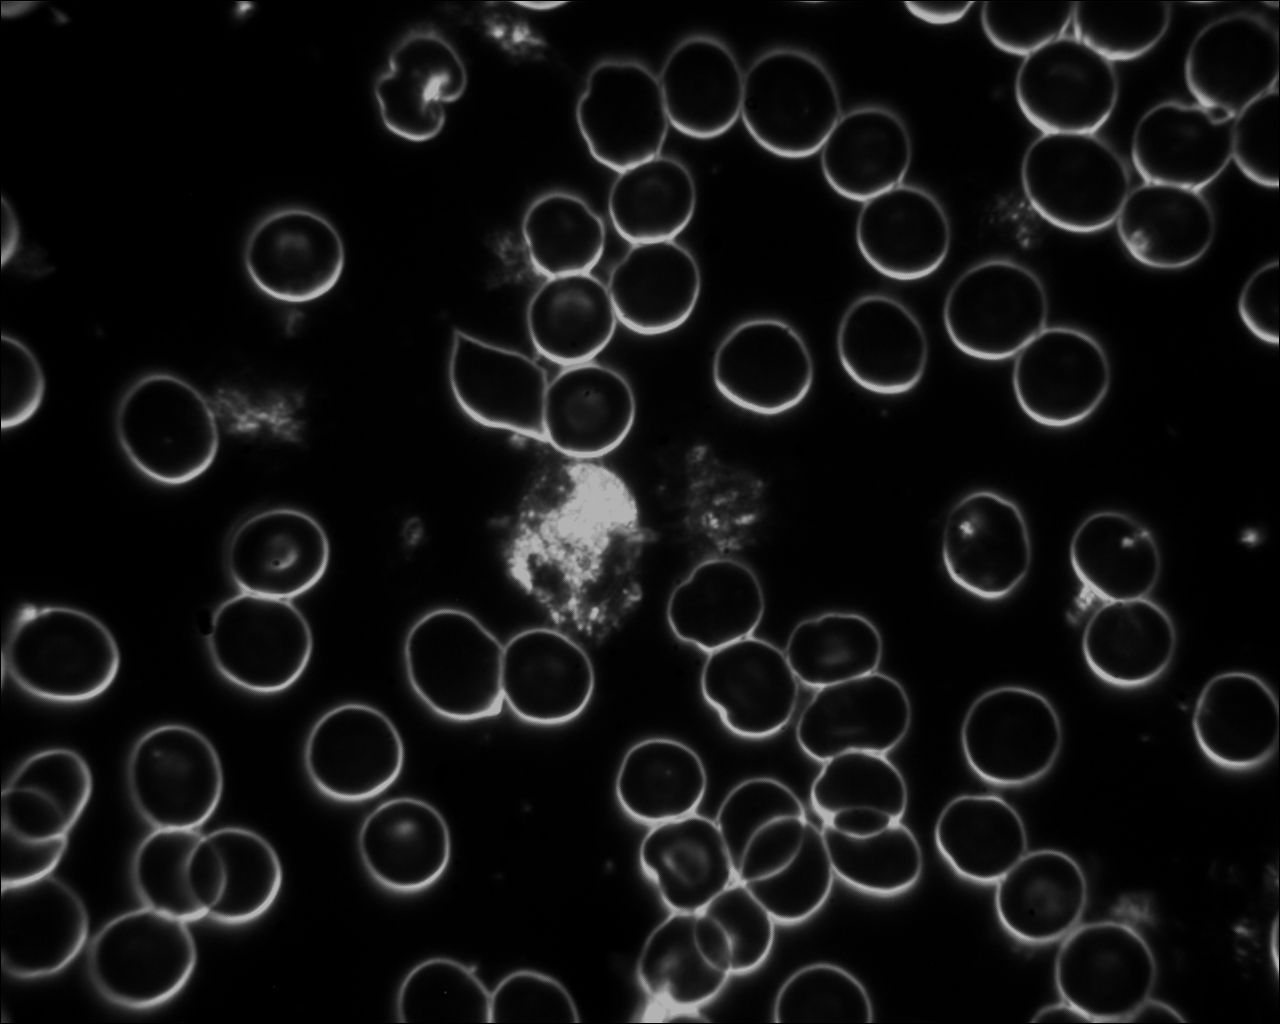

Atmen - weniger ist mehr
Weniger atmen - das klingt befremdlich, oder?
Doch warum genau dies für unseren Körper sinnvoll ist, dazu erfahren Sie hier ein paar Hintergründe:
Die Atmung dient dazu, den lebenswichtigen Sauerstoff mit der Atemluft aufzunehmen, in die Körperzellen zu transportieren und das anfallende Kohlendioxid abzugeben. Mit diesem Prozess stellt der Körper die Energie her, die wir zum Leben brauchen.
Dabei gibt es die Unterscheidung zwischen
äußerer Atmung und
innerer Atmung.
Mit dem Begriff
'äußere Atmung' ist die
Lungenatmung gemeint: Wir ziehen wir Luft über die Nase, den Rachen, die Luftröhre und die Bronchien in die Lunge ein. In den kleinsten Lungenbläschen, den Alveolen, wird der lebenswichtige Sauerstoff im Blut an die roten Blutkörperchen angeheftet. Diese transportieren ihn dann zu jeder Körperzelle.
Hier beginnt die
'innere Atmung', die auch
Zellatmung genannt wird. Der Sauerstoff wird von der Körperzelle aufgenommen und weiter zu den in der Zelle sitzenden Mitochondrien, den sog. Energiekraftwerken der Zelle, transportiert. Dort wird er mit Glukose in nutzbare Energie verwandelt, bekannt als ATP. Diesen Brennstoff brauchen wir für unsere Stoffwechselvorgänge und unser Leben. Als Abfallprodukte entstehen Wasser und Kohlendioxid.
Für eine gute Gesundheit, Fitness und Leistungsfähigkeit brauchen wir also eine gesunde Lunge, freie Transportwege und viele, gesunde Körperzellen sowie viele gut funktionierende Mitochondrien.
Gleichzeitig muß neben der Lungenatmung auch die Zellatmung, die innere Atmung, gut funktionieren. Und - wie geschieht das?
Zellatmung - die unbekannte Facette unserer Atmung
Jetzt wird’s spannend: Wir müssen weniger atmen!
Das klingt zunächst paradox, ist jedoch in vielen Studien untersucht und belegt worden. Beschrieben wird dieses Phänomen als
Bohr-Effekt, der besagt, dass bei steigendem Kohlendioxidgehalt der Sauerstoff leichter ins Gewebe abgegeben werden kann.
Wer hierzu tiefer in die Chemie eintauchen möchte, der sei verwiesen auf ausführlichere Beschreibungen, beispielsweise hier:
https://flexikon.doccheck.com/de/Bohr-Effekt - (Stand: 21.03.24)
Wenn weniger Sauerstoff als üblich im Gewebe ist, nennt man das Hypoxie. Dies geschieht durch reduziertes Atmen. Natürlich dürfen und können Sie den Sauerstoffgehalt nicht auf einmal deutlich reduzieren. Versuchen Sie mal, auf der Stelle zwei Minuten die Luft anzuhalten 😀 - geht nicht- außer Sie sind Apnoetaucher.
Sie können allerdings lernen und Ihren Körper trainieren, langsam das Atemvolumen zu reduzieren und mit weniger Sauerstoff auszukommen.
Wie gelingt die reduzierte Atmung?
Dazu gibt es zwei Wege:
- Sie üben
reduziertes Atmen in Ihrem Alltag. Ein guter Beginn ist, permanent durch die Nase zu atmen. Zusätzlich sind gezielte Atemübungen erforderlich. Anleitung und Unterstützung erhalten Sie in meinen
Einzelberatungen oder auch
Atemkursen.
Nehmen Sie bei Interesse gerne hier Kontakt auf. - Sie nutzen ein sogenanntes Hypoxie-Training. Hier können Sie mit einem Hypoxie-Trainingsgerät unter kontrollierten Bedingungen und guter Überwachung der Herz-Kreislauffunktionen Ihren Körper trainieren. In meiner Praxis können Sie dies im Rahmen des IHHT-Trainings nutzen. Hier erhalten Sie dazu mehr Informationen: